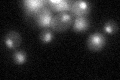
YDR207C
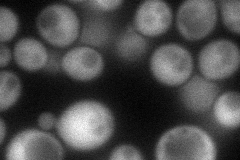
YDR207C
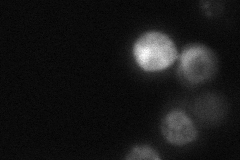
YDR207C

View description
Key transcriptional regulator of early meiotic genes, binds URS1 upstream regulatory sequence, couples metabolic responses to nutritional cues with initiation and progression of meiosis, forms complex with Ime1p, and also with Sin3p-Rpd3p
Localization:
Intensity:
Fold change:
Significance:
-
C’ GFP library in SD
nucleus24.43 -
N' NOP1pr-GFP in SD
cytosol63.8191 -
N' TEF2pr-mCherry in SD

cytosolN/A -
N' NATIVEpr-GFP in SD
punctate17.3222 -
N' TEF2pr-VC and Cyto-VN in SD

cytosol28.3956 -
C’ GFP library in SD+DTT

nucleusN/AN/ANo -
C’ GFP library in SD+H2O2

nucleusN/AN/ANo -
C’ GFP library in Starvation Media

nucleusN/AN/AYes -
C’ GFP library on the background of Pup2-DaMP

nucleus -
C’ GFP library on the background of CCT mutant

nucleusN/AN/ANo
